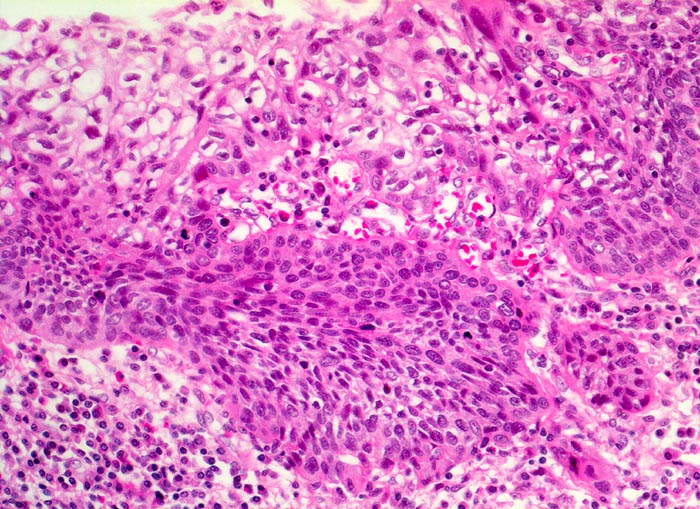

PathoPic – image database / PathoPic ID 5028 - Carcinoma in situ der Ösophagusschleimhaut mit beginnender Invasion
de
Diagnose
Carcinoma in situ der Ösophagusschleimhaut mit beginnender Invasion
Diagnose Gruppe
maligner Tumor
Topographie
Oesophagus, distal
Topographie Gruppe
Oesophagus, Magen
Beschreibung
Das schwer dysplastische Epithel bildet unregelmässige Zapfen, die in das Stroma vordringen. Fährt man an der Basis entlang, erkennt man an einer Stelle eine zipflige Tumorinvasion des Stromas. An dieser Stelle ist keine Basalmembran erkennbar. Die Submukosa enthält ein dichtes gemischtes Entzündungsinfiltrat.
Klinik
Jahrelanger Nikotin- und Ethylabusus. Vor 6 Monaten ergab die Abklärung wegen progredienter Dysphagie ein inoperables stenosierendes Karzinom im distalen Ösophagus. Der Patient verstirbt am Tumorleiden.
Bilder Typ
Histologie
Vergrösserung
200
Alter
60
Geschlecht
männlich
Datum
Ersteintrag: 13.06.2002
Update: 04.02.2024